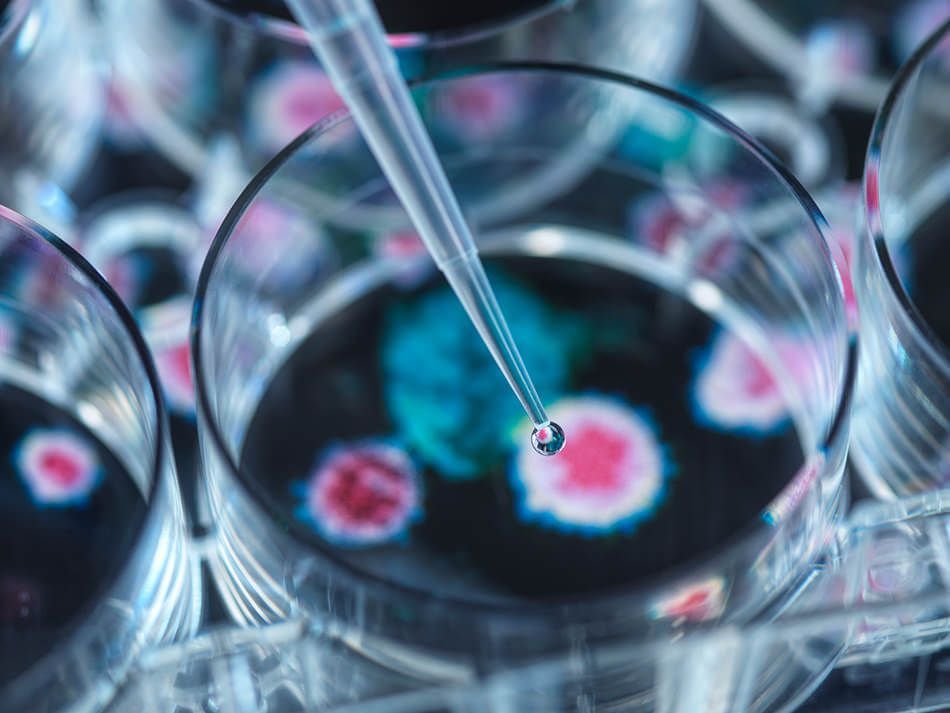

The only technology that delivers uninterrupted protection from viruses, bacteria and the superbug!
Our company is proud to represent RESYSTEN® in the U.S. and in LATAM and to make this NEXT LEVEL HYGIENE available and accessible to protect everyone’s health. RESYSTEN® delivers 12 months of protection against superbugs, viruses, bacteria, mold and mildew on virtually any surface. Finally a non toxic, environmentally friendly product that protects everyone and everything! This groundbreaking, disinfecting and sanitation technology was developed to safely treat and protect surfaces ranging from plastic, to metal, fabric, wood, paint, to textile among many others. Our product also purifies air, neutralizes odor and significantly reduces VOC (Volatile Organic Compound) emissions. Hospital and healthcare facilities, public transportation and transportation hubs, schools and educational facilities, hotels and hospitality, corporate office buildings, sporting and recreational facilities, governmental and municipal facilities are some examples of places where hundreds of people gather and are exposed to deadly microorganisms. With RESYSTEN’s protective coating we can finally control the spread of contamination, promote a safer environment and keep our population healthy. No more flue, e.coli, SARS, H1N1 or coronavirus spreads!
With this protective coating, which is delivered via nano-technology, surfaces are free from pathogens for a whole year with a 95% reduction rate. Door handles, handrails, bathrooms, touch screen devices, keyboards, tables, chairs, elevator buttons etc. are some of the most common hotspots that collect bacteria 24/7. People touch those surfaces and on average 100 surfaces per day. According to expert studies 80% of infections are spread by touch! Our coating stops surface contamination on the spot. It delivers unrivaled protection and saves substantial amounts on sanitation detergents and chemicals. It also extends the shelf life of products, equipment and furniture where the coating is applied, removes bad odor including in toilets and in smoking rooms, it minimizes the risk of restaurant and hospital illnesses, eliminates human error that may occur in daily cleaning protocols, reduces sick leave at the workplace, and delivers great optics for businesses that want to maintain and comply with corporate social responsibility. RESYSTEN® protects everyone, employees and customers, and promotes a healthier, safer and more productive working environment, all while significantly lowering environmental impact.